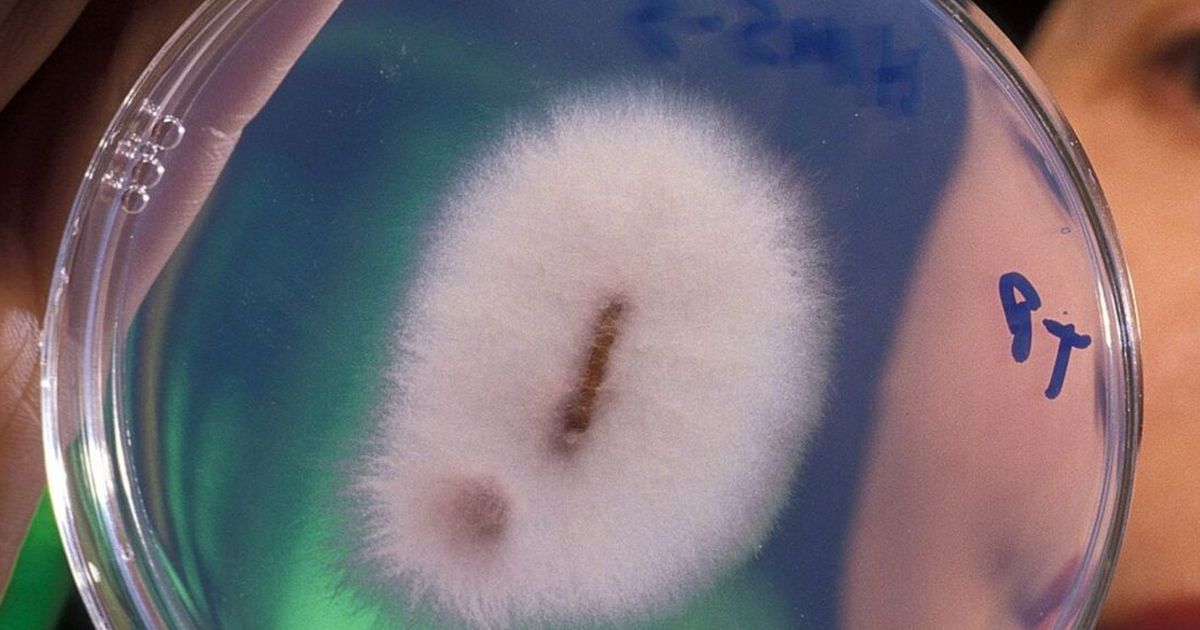
{{caption}}

Harga Jamur Ini Lebih Mahal dari Emas, Tembus Rp2,3 Miliar Per Kilogram, Begini Khasiatnya
Jamur ini hanya tumbuh di tempat tertentu, biasanya di dataran tinggi.

Jamur ini hanya tumbuh di tempat tertentu, biasanya di dataran tinggi.

Harga Jamur Ini Lebih Mahal dari Emas, Tembus Rp2,3 Miliar Per Kilogram, Begini Khasiatnya
Jamur zombie Cordyceps sinensis adalah parasit yang disebut-sebut bernilai lebih dari harga jual emas bagi pembeli yang tepat. Jamur ini diincar karena dipercaya memiliki khasiat untuk mengobati penyakit tertentu.
Jamur ini menjadi sumber pendapatan penting bagi sebagian orang, namun terancam punah akibat perubahan iklim dan penggunaan yang berlebihan.
Sumber: IFL Science

Menurut penelitian, jamur zombie bekerja dengan menangkap inangnya, memanipulasi sistem saraf mereka sehingga mereka berperilaku dengan cara yang bermanfaat untuk penyebaran spora.
Pada manusia, Cordyceps adalah parasit. Larva ngengat hantu merupakan korban dari jamur ulat yang sangat berharga ini. Jamur ini ditemukan pada ketinggian di atas 4.500 meter di Bhutan, Cina, India, dan Nepal. Jamur ini dikenal sebagai ‘yartsa gunbu’ atau DongChongXiaCao, yang berarti ulat musim dingin dan rumput musim panas.
Julukan ‘zombie’ untuk jamur ini sangat tepat karena sporanya menyerang tubuh ulat, dan membuat mereka menuju permukaan tanah di mana mereka akan mati.


Cordyceps tidak aktif di musim dingin, namun keluar dari kepala ulat menuju sinar matahari di musim semi.
Spora yang keluar dari jamur bebas melayang ke lingkungan, dan selanjutnya menginfeksi lebih banyak ulat. Tonjolan panjang seperti tongkat yang keluar dari kepala mereka sering disalahartikan sebagai cacing, faktanya itu adalah tubuh buah Cordyceps sinensis.
Jamur ‘zombie’ ini dihargai sekitar Rp2,3 miliar per kilogram di China dengan nilai pasar global sebesar Rp174,5 triliun, lapor New Scientist.
Yartsa gunbu menghasilkan keuntungan yang cukup besar, karena produksi yang sangat sulit. Tanaman ini membutuhkan pencarian makanan di ketinggian yang setara dengan Base Camp Everest atau 5.364 meter di atas permukaan laut, sehingga dapat menarik ulat cacing setiap tahun karena orang-orang berduyun-duyun mencari buahnya.Dengan masa panen yang terbatas selama dua bulan, dan banyak kolektor yang bergantung pada pendapatan Cordyceps, panen yang berlebihan hingga perubahan iklim menyebabkan produksi jamur ini menurun dan lebih sulit untuk berkembang biak. Setiap tahun semakin sulit untuk menemukan ulat yang terparasit, yang menjadi siklus yang mengubah rumput musim dingin-musim panas menjadi jamur termahal di dunia.
Perusahaan-perusahaan sekarang mencari alternatif untuk membudidayakan Cordyceps secara artifisial karena ditemukan bahwa mereka memiliki kandungan nutrisi yang sama dengan makhluk sejenis yang liar dan langka. Meskipun ini merupakan solusi untuk masalah keberlanjutan, ini bukanlah pendekatan yang berkelanjutan bagi para petani yang mengandalkan ulat untuk mendapatkan penghasilan.
Terdapat garis tipis yang harus dilalui antara melestarikan jamur zombie yang unik ini dan praktik tradisional yang telah berlangsung selama seribu tahun, tetapi patut untuk dipertimbangkan.

























:strip_icc():format(webp)/kly-media-production/medias/8261884/original/074420100_1781761634-IMG-20260220-WA0039.jpg)
:strip_icc():format(webp)/kly-media-production/medias/8261817/original/031020200_1781758697-769133.jpg)
:strip_icc():format(webp)/kly-media-production/medias/8261560/original/020942400_1781744954-AP26168812020257.jpg)
:strip_icc():format(webp)/kly-media-production/medias/8261730/original/044268900_1781756195-IMG_3586.jpeg)
:strip_icc():format(webp)/kly-media-production/medias/8261539/original/051141200_1781743137-IMG-20260618-WA0008.jpg)
:strip_icc():format(webp)/kly-media-production/medias/7756816/original/058572900_1780566030-IMG_1673.jpeg)